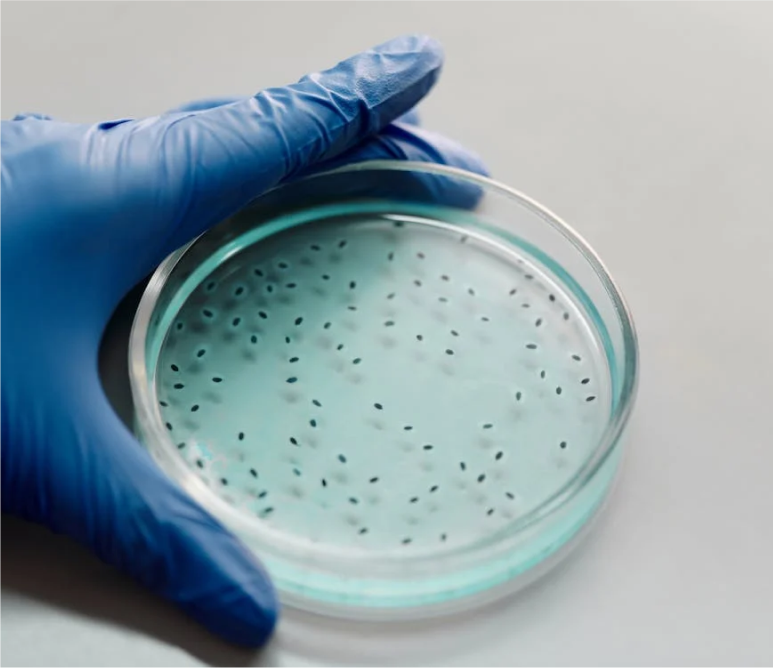
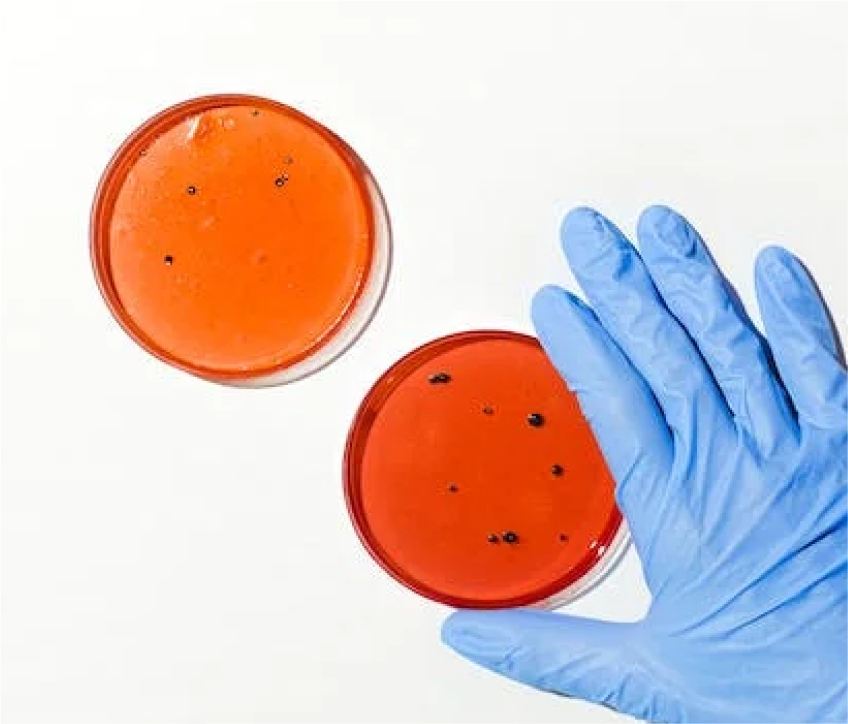

Research Consultation Services
Dr. Rizwan Iqbal has been working in the field of medical research since 1986 and served Pakistan Medical Research Council for 34 years and retired as Research Director.

Dr. Rizwan Iqbal has been working in the field of medical research since 1986 and served Pakistan Medical Research Council for 34 years and retired as Research Director.

Medical Research provides you with one-on-one consultation and assistance for all of your dissertation and thesis research and statistics needs from start to finish. Regardless of where you are in the dissertation or thesis process, Top Medical Research can help you complete your research or statistics project quickly and efficiently.
We work in coordination with the comments and suggestions of your dissertation or thesis advisor and committee. We carefully modify your documents to ensure that it is 100% grammatically correct with tracked changes in your document.

Final checking of your dissertation and thesis of MPhil and PhD

From picking your research topic to discovering fresh sources and from literature reviews to working with rare and unique materials and data.

Offer other kinds of support tailored for your research needs.

Research Questions and Hypotheses (supervise your research proposal writing in standard format).
Worked with 200+ thesis
Worked with 100+ students
Depends on the thesis
© 2026 All Rights Reserved.
is proudly powered by WordPress